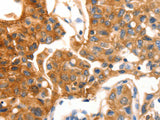
MVP Polyclonal Antibody Store at -20°C

MVP Polyclonal Antibody Store at -20°C
SKU: E-AB-10434-200
MVP Polyclonal Antibody Store at -20°C
| SKU # | E-AB-10434 |
| Reactivity | Human, Mouse, Rat |
| Host | Rabbit |
| Applications | WB, IHC |
Product Details
| Isotype | IgG |
| Host | Rabbit |
| Reactivity | Human, Mouse, Rat |
| Applications | WB, IHC |
| Clonality | Polyclonal |
| Immunogen | Recombinant protein of human MVP |
| Abbre | MVP |
| Synonyms | LRP, Lung resistance related protein, Lung resistance-related protein, MVP, Major vault protein, VAULT 1, VAULT1, homolog of, rat, testicular secretory protein Li 30 |
| Swissprot | |
| Calculated MW | 99 kDa |
| Cellular Localization | Cytoplasm. Nucleus>nuclear pore complex. 5% found in the nuclear pore complex. Translocates from the nucleus to the cytoplasm upon EGF treatment. |
| Concentration | 0.3 mg/mL |
| Buffer | Phosphate buffered solution, pH 7.4, containing 0.05% stabilizer and 50% glycerol. |
| Purification Method | Affinity purification |
| Research Areas | Cancer, Signal Transduction |
| Conjugation | Unconjugated |
| Storage | Store at -20°C Valid for 12 months. Avoid freeze / thaw cycles. |
| Shipping | The product is shipped with ice pack,upon receipt,store it immediately at the temperature recommended. |
Related Reagents
| Applications | Recommended Dilution |
| WB | 1:500-1:2000 |
| IHC | 1:50-1:200 |
Background
This gene encodes the major component of the vault complex. Vaults are multi-subunit ribonucleoprotein structures that may be involved in nucleo-cytoplasmic transport. The encoded protein may play a role in multiple cellular processes by regulating the MAP kinase, JAK/STAT and phosphoinositide 3-kinase/Akt signaling pathways. The encoded protein also plays a role in multidrug resistance, and expression of this gene may be a prognostic marker for several types of cancer. Alternatively spliced transcript variants have been observed for this gene.